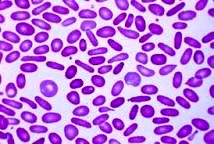
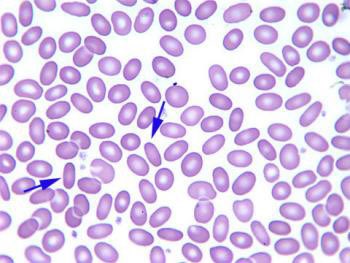
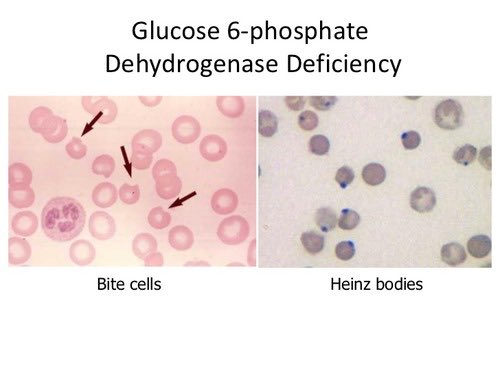

في هذه #السلسلة نكمل في أمراض الدم الوراثية و الجينات
و موضوعنا الأول عن
hereditary elliptiocytosis او ovalocytosis
نستفيد من الوقت و نراجع @ArabBioMed @Biology1802 @lab_phot @almohammadi77 @MoayadZakri @mymzakari @AfghaniHani @adeelchaudhary
و موضوعنا الأول عن
hereditary elliptiocytosis او ovalocytosis
نستفيد من الوقت و نراجع @ArabBioMed @Biology1802 @lab_phot @almohammadi77 @MoayadZakri @mymzakari @AfghaniHani @adeelchaudhary
-النقص المتماثل homozygous ينتج عنه حالة حادة من الأنيميا
-في الفحص المجهري يكون شكل الخلايا غريب bizarre blood
-اما في حالات ال heterozygous تكون الأعراض فوق المتوسطة
-في الفحص المجهري يكون شكل الخلايا غريب bizarre blood
-اما في حالات ال heterozygous تكون الأعراض فوق المتوسطة
-منتشر عند من هم جنوب شرق اسيا
-خصوصا في المناطق المنتشر فيها الملاريا
- الأعراض تشمل الاصفرار في الجلد والعين
- صعوبة في التنفس و تضخم الطحال و ظهور الحصوات
- في الحالات المتقدمة نقل الدم مطلوب و كذلك و التخلص من الطحال splenctomy
-خصوصا في المناطق المنتشر فيها الملاريا
- الأعراض تشمل الاصفرار في الجلد والعين
- صعوبة في التنفس و تضخم الطحال و ظهور الحصوات
- في الحالات المتقدمة نقل الدم مطلوب و كذلك و التخلص من الطحال splenctomy
-التغيير او mutation في نسخة واحدة من الجين SLC41 يحمي من المضاعفات العصبية للملاريا
-ولكن ال mutation في النسختين مميت للاطلاع rarediseases.info.nih.gov
-ولكن ال mutation في النسختين مميت للاطلاع rarediseases.info.nih.gov
دور هذا الأنزيم مهم في حمل الأكسجين من الرئة لمختلف الأنسجة في الجسم
ويحمي خلايا الدم الحمراء من موتها او تكسرها قبل عمرها
- له دور في التفاعل بين NADPH و NADP
- مسؤول عن انتاج GSH
ويحمي خلايا الدم الحمراء من موتها او تكسرها قبل عمرها
- له دور في التفاعل بين NADPH و NADP
- مسؤول عن انتاج GSH
و دور NADPH يلعب دور مهم في حماية الخلايا من مواد ضارة جدا اسمها ROS (reactive oxygen species)و بالتالي اي نقص في هذا الأنزيم يسبب خلل في تكوين NADPH و النتيجة عدم توفر الحماية لخلايا الدم الحمراء و عرضتها للضرر اكثر و للتكسر
- له نوعين، الأول type A (African) وهو الأغلب
- والنوع الثاني type B (western)
- النقص في هذا الأنزيم يودي الى نقص في GSH
- اذا ماهو ال GSH
- يحمي الهيموجلوبين و غشاء RBC من oxidant stress
- والنوع الثاني type B (western)
- النقص في هذا الأنزيم يودي الى نقص في GSH
- اذا ماهو ال GSH
- يحمي الهيموجلوبين و غشاء RBC من oxidant stress
عوامل مثل العدوى و بعض أنواع الأدوية و اكل الفول (البقوليات)حتى ما يسمى باللغة العربية أنيميا الفول كلها تزيد من مستوى ROS مما يجعل RBC تتحلل و تتكسر مبكرا premature death @ForensicToxi @fayezalrosan
اكثر من ٢٠٠ mutation التي تسبب ضعف و نقص في G6PD تم التعرف عليها و كلها مرتبطة في amino acids
موجودة في الكروموسوم الذراع الطويل long arm في الكروموسوم ٢٨. للاطلاع و الفائدة #synonyms" target="_blank" rel="noopener" onclick="event.stopPropagation()">ghr.nlm.nih.gov
موجودة في الكروموسوم الذراع الطويل long arm في الكروموسوم ٢٨. للاطلاع و الفائدة #synonyms" target="_blank" rel="noopener" onclick="event.stopPropagation()">ghr.nlm.nih.gov
جاري تحميل الاقتراحات...